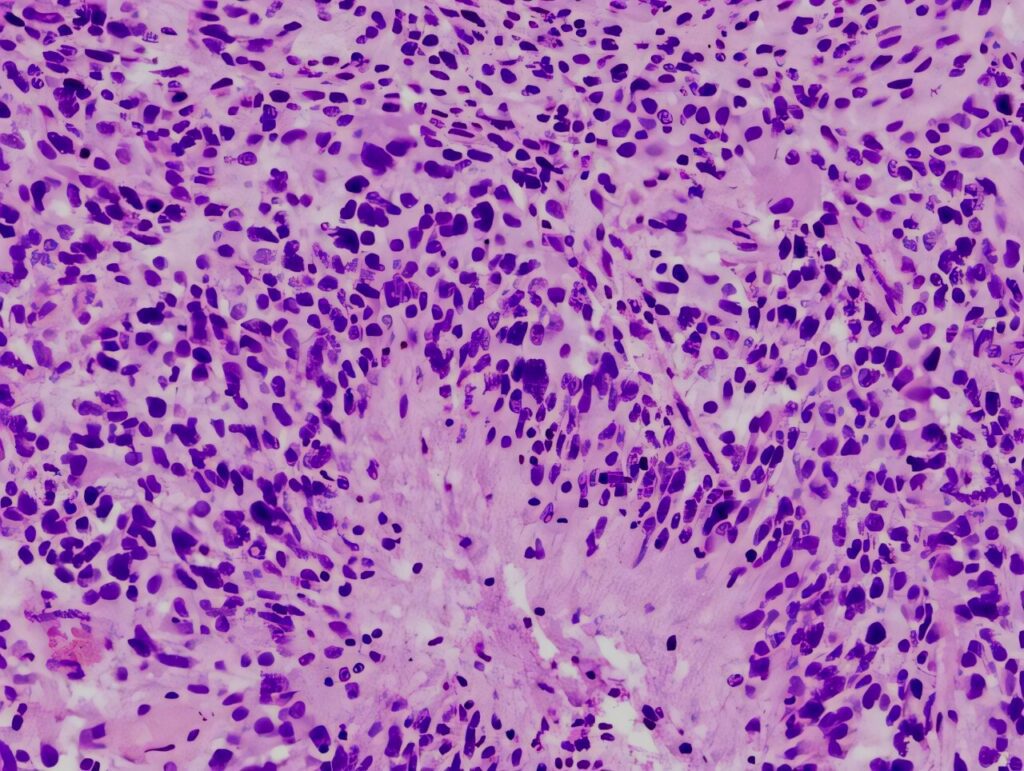

- Metastases
- Glioblastoma
- Anaplastic astrocytomas
- Medulloblastoma
- Lymphoma
- Gliosarcoma
- Chordoma
- Chondrosarcoma
Leading experts in neuro-oncology
neurosurgery | systemic oncological treatment | radiation therapy | rehabilitation
Neuro-oncology institute
Neuro-oncology Institute led by Prof. Gerardo Conesa is a multifunctional medical facility specialized on complex treatment of benign and malignant tumors of the nervous system: brain tumors, spinal tumors and spinal cord tumors.
Experience of our specialists and technical equipment of the hospital allows us
to offer the best treatment for every patient.
Watch the video to know more.

Leading doctors

Prof. Gerardo Conesa
Director of Neuro-Oncology Institute, Leading neurosurgeon
Prof. Conesa is the Director of the Institute of Neurosurgery and Neuroscience at Teknon Medical Centre. He earned his medical degree from the University of Barcelona in 1982 and completed his neurosurgery specialization at the University Hospital de Bellvitge in 1990. His training includes internships in both the United States and France, and since 1985 he has served in several university hospitals across Barcelona. He is an active member of numerous professional organizations, including the European Association of Neurosurgical Societies, the European Union of Neurosurgeons, the Spanish Society of Neurosurgery, and the Walter E. Dandy Society.
30+ years of clinical experience
Specialization
- Brain tumors :glioma, glioblastoma, meningioma, neurinoma, brain metastases.
- Lumbar and cervical spine surgery: minimally invasive procedures.
- Epilepsy surgery and Deep Brain Stimulation (DBS).
Diagnosis & diagnostic methods
Neuro-oncology is the specialized medical discipline focused on the comprehensive diagnosis and management of primary and secondary neoplasms affecting the central nervous system (CNS), encompassing the brain, spinal cord, and spine. Many of these pathologies, such as astrocytomas, gliomas, glioblastomas, and brainstem tumors, are characterized by high aggressiveness and a significant mortality risk.
Optimal therapeutic efficacy mandates a multimodal approach, integrating neurosurgery with systemic oncology treatments and precision radiation therapy.
Due to the inherent heterogeneity of tumor types, patients typically present with varied and complex neurological symptoms, necessitating a thorough diagnostic workup utilizing multiple specialized tests.
Most common types of brain tumors
-
Typically Malignant Brain Tumors
-
Typically Benign Brain Tumors
- Diffuse astrocytoma
- Oligodendroglioma
- Pilocitic astrocytoma
- Ependimoma
- Subependimoma
- Hemangioblastoma
- Pineal tumors: pineocytoma
- Meningioma
- Pituitary Adenoma
- Craniopharyngioma
- Schwannoma
- Choroid Plexus
- Tumor
- Dysembryoplastic
- Neuroepithelial
- Tumor (DNET)
- Epidermoid cyst
-
Brain Tumors with Variable Grades (From More Benign to Malignant)
- Astrocytomas
- Oligodendrogliomas
- Subependymoma
- Myxopapillary ependymoma
- Ependymoma
- Hemangiopericytoma
- Germ Cell Tumors
- Pineal Tumors
Most common types of spine & spinal cord tumors
-
Typically Malignant Spinal Tumors
- Osteosarcoma
- Chondrosarcoma
- Multiple myeloma
- Lymphoma
- Chordoma
- Ewing´s sarcoma
- Metastases of other tumors
-
Typically Benign Spinal Tumors
- Meningioma
- Ependymoma and subependymoma
- Hemangioblastoma
- Astrocytoma
- Hemangioma
- Osteoid osteoma
- Osteoblastoma
- Osteochondroma
- Giant cell tumor
- Epidermoid cyst
Diagnostic
-
Symptoms evaluation
In neuro-oncology, careful evaluation of symptoms plays a crucial role in the early detection and management of brain and spinal cord tumors. Symptoms can vary widely depending on the location of the tumor, its size, growth rate, and biological aggressiveness...
Read article -
CT scan
Computed Tomography (CT) scans play an important role in the diagnosis and management of neurological conditions, including brain and spinal disorders...
Read article -
MRI SCAN
Magnetic Resonance Imaging (MRI) is the primary imaging modality in neuro-oncology and plays a central role in the diagnosis, treatment planning, and follow-up of brain and spinal cord tumors. Its ability to provide detailed images of soft tissue makes MRI...
Read article -
PET SCAN
Positron Emission Tomography–Computed Tomography (PET-CT) is an advanced imaging technique that provides unique insight into the biological activity of brain and spinal tumors...
Read article -
Biopsy, histology, immunological & genetic tests
In neuro-oncology, understanding the biology of a brain or spinal tumor is essential for selecting the most effective and individualized treatment plan. Diagnostic tools such as biopsy, histology, immunohistochemistry, and molecular testing are required to accurately classify...
Read article
Treatment
Neurosurgical treatment
Treatment planning is tailored to the disease stage, tumor type, and location. Therapeutic options include neurosurgery, systemic therapy, and radiation therapy, or a combination thereof. The optimal plan is determined by a multidisciplinary medical consilium.
Neurosurgical intervention is performed whenever feasible and advantageous to the patient's outcome. Based on the individual clinical presentation, the tumor may undergo complete removal (extirpation) or partial removal (resection).
-
Complete removal or extirpation of the tumor
In almost all cases where the tumor is technically amenable to complete surgical removal, prompt intervention is highly recommended. This action is paramount for mitigating further disease progression and optimizing the patient's overall prognosis.
It must be noted, however, that certain tumor histologies inherently carry a high risk of recurrence even following successful primary extirpation. To consolidate the surgical outcome and prevent relapse, subsequent adjuvant therapy, typically comprising radiation and systemic oncological treatments, is often required.
-
Partial removal or resection of the tumor
When the location of the tumor or its closeness to vital areas makes complete removal unsafe, the medical team may recommend a partial removal (resection).
The main goal of this procedure is maximal safe debulking: removing the largest amount of the tumor possible without causing harm. This is done to significantly reduce the number of cancer cells before other treatments begin, which ultimately improves the patient's long-term outcome and lowers the chance of complications.
Special technologies for neurosurgery
The Neuro-oncology Institute is equipped with cutting-edge technology to ensure every surgical procedure is both highly effective and maximally safe.
We utilize advanced tools for microsurgery, real-time imaging during operation, precise neuronavigation, and continuous neuromonitoring.
These measures work together to protect healthy tissue and prevent the loss of critical neurological functions.
-
Best Digital Visualization
KINEVO ZEISS 900 Microscope with Quevo endoscopic system
Complex neurosurgeries utilize the ZEISS KINEVO 900 Microscope with the QEVO endoscopic system, which delivers exceptional digital and optical visualization via cutting-edge 4K 3D camera technology. This high-definition precision allows surgeons to confidently distinguish subtle tissue differences and critical anatomical structures. Ultimately, this technology ensures safer, more complete tumor removal for the patient while rigorously preserving healthy neural function.

-
Intraoperative neuronavigation
The StealthStation™ S8
The surgical navigation system uses advanced, real-time tracking technology to precisely guide surgical instruments throughout a procedure. By seamlessly integrating imaging, navigation, powered tools, bleeding control, and surgical implants, the system helps surgeons operate with greater accuracy and confidence. For patients, this means more precise procedures, reduced disruption to surrounding tissue, and a strong focus on safety—supporting improved outcomes and a smoother recovery.

-
Intraoperative Neurophysiological Monitoring
Intraoperative Neurophysiological Monitoring (IONM) is a real-time monitoring technique used during surgery to assess the functional integrity of critical neural structures, including the brain, spinal cord, and peripheral nerves. By continuously providing immediate feedback to the surgical team, IONM helps detect potential stress or injury to neural pathways as it occurs. This allows surgeons to make timely adjustments during complex procedures—such as spinal, brain, or vascular surgeries—helping to reduce the risk of neurological injury, improve surgical outcomes, and support safer recovery for patients.

-
Fluorescence Imaging
ZEISS BLUE 400 S – Fluorescence Oncology with 5-ALA
The system with 5-ALA marker, provides high-quality visualization during neurosurgery to help surgeons identify tumor tissue associated with Grade III and IV gliomas. Enhanced clarity—particularly of both fluorescent and non-fluorescent tissue—supports more accurate differentiation between tumor and healthy brain tissue. For patients, this improved visualization helps surgeons remove as much tumor as safely possible while preserving surrounding healthy tissue, supporting better surgical outcomes and neurological safety.

-
Endoscopic neurosurgery
Endoscopy is applied for skull Base and sentricular tumors. It is a minimally invasive technique that uses a small camera and light to access tumors at the skull base or within the brain’s ventricles, often through the nasal passages or tiny incisions. This approach provides clear visualization while minimizing disruption to healthy brain tissue.
For patients, it typically means less trauma, fewer complications, and faster recovery compared to traditional open surgery.

Systemic oncological treatment
Systemic oncological treatments represent a cornerstone of comprehensive neuro-oncology management. These drug therapies are designed to eliminate residual microscopic disease and mitigate the risk of tumor progression or recurrence, often serving as adjuvant treatment following primary surgical and radiation interventions.
The systemic approach utilizes several distinct modalities, including chemotherapy, targeted therapy, and immunotherapy.
-
Chemotherapy
Chemotherapy refers to a category of medications used to treat malignant tumors by inhibiting tumor growth and reducing tumor burden. These drugs are administered intravenously or taken orally as tablets.
Despite its intimidating reputation, chemotherapy remains one of the most extensively studied cancer treatments.
While side effects are common, its toxicity profile is not inherently more severe than modern therapies like immunotherapy or targeted therapy; the impact varies depending on the regimen and patient-specific factors.
-
Immunotherapy
Immunotherapy is a cancer treatment modality designed to bolster the immune system’s ability to combat cancer. Approaches include checkpoint inhibitors, cancer vaccines, oncolytic viral therapy, and CAR T-cell therapy.
While its application in brain tumors remains limited, immunotherapy is now standard for certain cancers (e.g., melanoma, lung cancer) and is under active investigation through clinical trials to expand its utility.
-
Targeted therapy
Targeted therapy focuses on blocking specific molecular markers (such as proteins or genes) that drive cancer cell proliferation, survival, and metastasis. These therapies are designed for tumors with identifiable molecular targets, forming the foundation of precision medicine.
A comprehensive molecular profile of the tumor is essential not only for diagnosis but also to guide treatment selection. For example, targeted therapies are already approved for tumors with BRAF mutations, IDH1/2 mutations, H3 K27M alterations, NTRK fusions, or FGFR abnormalities. Ongoing research is rapidly expanding the list of therapeutic targets, with significant advancements expected in the coming years.
Radiation therapy
Radiation therapy is an essential component of neuro-oncology management, utilized either pre-operatively (neoadjuvant), post-operatively (adjuvant), or as the primary intervention when anatomical or clinical factors preclude surgical resection.
Two principal methodologies are employed: classical photon-based radiation therapy (delivered via a linear accelerator) and the highly advanced proton therapy (which uses charged particles). We are equipped to offer both of these critical, state-of-the-art treatment modalities.
-
Photon-based radiation therapy Truebeam
The high-precision TrueBeam system from Varian, installed at the Teknon Medical Center, utilizes advanced stereotactic navigation to accurately calculate the trajectory and dosage of radiation. This system uses photon radiation therapy, which involves high-energy X-rays, to achieve the desired effect with a minimal radiation dose, thus preventing the development of complications.
However, in specific cases, a more modern method of tumor irradiation—proton therapy—may be recommended.
-
Proton therapy Proteus-one from IBA
Proton therapy is a highly specialized form of radiation that uses charged particles (protons) instead of X-rays. Because protons can be precisely controlled to deposit their energy directly at the tumor site and stop, this method often allows for significantly less damage to healthy surrounding tissues, which can lead to a more favorable prognosis in certain cases.
As a key part of the Quironsalud network, the Teknon Medical Center seamlessly facilitates patient access to this advanced proton therapy, which is administered at the specialized Quironsalud Proton Therapy Center in Madrid.
Additional treatment
Beyond the primary oncological treatments, our approach integrates several adjunctive and supportive therapies designed to enhance the patient's overall quality of life and functional recovery.
These include specialized options like Tumor-Treating Fields (TTFields) to disrupt cancer cell proliferation, alongside physiotherapy and rehabilitation for physical recovery, and robust supportive care measures focused on pain management, nutritional guidance, and psychological well-being.
-
Tumor Treating Fields (TTFields) — OPTUNE
TTFields target rapidly dividing tumor cells by interfering with mitosis during cell division. This mechanism preferentially affects cancer cells over healthy, non-dividing cells. It’s a device that is put on the head of a patient: the scalp is shaved, and four electrode arrays are placed directly on the skin.
The arrays connect to a portable, battery-powered generator (carried in a backpack), which delivers continuous electric fields to the tumor. Treatment requires near-daily use (≥18 hours/day) for optimal efficacy.

Articles
-

Glioblastoma: Symptoms, Diagnosis, and Treatment
Glioblastoma is the most aggressive primary malignant tumor of the central nervous system in adults. It represents the highest-grade form of diffuse glioma and is characterized by rapid growth, extensive infiltration of surrounding brain tissue, and complex molecular heterogeneity.
Read article -

Meningioma: Symptoms, Diagnosis, and Treatment
Meningiomas are among the most common primary brain tumors, affecting thousands of people each year. Although most meningiomas are benign (non-cancerous), their size and location can still lead to significant neurological problems.
Read article -

Diffuse Astrocytoma: Symptoms, Diagnosis, and Treatment
Diffuse astrocytoma is a primary tumor of the central nervous system arising from astrocytic glial cells. It belongs to the group of infiltrative gliomas and is characterized by slow to moderate growth, diffuse infiltration of surrounding brain tissue, and a variable clinical course.
Read article -

Radiation Therapy in Neurooncology: Principles, Indications, and Long-Term Outcomes
Radiation therapy is a fundamental component of modern neurooncology and plays a central role in the treatment of both primary and metastatic tumors of the central nervous system
Read article
Hospital
Located at the Teknon Medical Center, one of the largest multidisciplinary hospitals in Spain, the Neuro-oncology Institute guarantees patients access to immediate, comprehensive medical support and expert postoperative care.
Teknon's dedication to quality is confirmed by 8 successful accreditations from Joint Commission International (JCI), ensuring high standards of safety. The hospital's versatility, supported by over 400 doctors and 2,000 specialists, allows for effective management of any potential complications.
This multidisciplinary environment ensures a complete recovery strategy, including individualized diet planning and dedicated physiotherapy.
“Teknon Medical Centre — the best international hospital”
IMTJ: International Medical Travel Journal


For patients
-
Initial evaluation
Neuro-oncology institute provides initial evaluation free of charge. Physician assistant will be in touch to gather the necessary information regarding your inquiry and organize your comprehensive case preparation ahead of your consultation with leading doctors.
-
Prepare your medical data
Send your medical reports, CT scans, and MRI scans directly to your medical assistant. They will ensure your case file is thoroughly prepared and that no crucial information is overlooked.
-
Get an online consultation with the leading doctors
Consult with our expert physicians remotely. Participate in a secure video call to review and finalize your treatment plan, culminating in the provision of a comprehensive official medical report.
-
Coordinate your arrival and Initiate therapy
Upon finalizing your treatment decision, our medical assistant will promptly prepare a comprehensive cost estimate and provide full assistance with organizing your visit for treatment. The clinic also offers dedicated visa support services for international patients.
-
Treatment & hospitalization
Accommodation is provided in private, high-comfort rooms featuring views of the Barcelona city. Care encompasses daily medical rounds, ensuring vigilant, continuous medical monitoring throughout the hospital stay.
-
Long-term recovery & follow-up
Our commitment to your care extends beyond your hospital stay; we maintain contact to monitor your progress and the treatment results. Our medical team remains readily available to address any questions you may have.
Testimonials
-
Brain aneurysm
"I can only say that on Three Kings' Day in 2002, I suffered a brain aneurysm and was taken to Bellvitge Hospital. Dr. Conesa operated on me and treated me during the month of January that I was hospitalized. Thanks to him and to God, he saved my life, and today I am in perfect health."
Anonymous patient
-
"Excellent, humane, and very personal service. Dr. Conesa explained everything very clearly; he's a true professional and a wonderful person. I highly recommend him."
V.L.
-
"The medical evaluation by Dr. Gerardo Conesa is worthwhile; he provides an excellent neurological assessment and is an expert neurosurgeon."
C.R.
-
"Everything...!!! His ability to improvise, his desire to help and heal, and above all his knowledge to achieve the impossible... When in another city and other neurosurgeons didn't want to or dare to operate on me to solve my inability to move... Thanks to him I have recovered an absolutely normal life."
Anonymous patient
For doctors
The Neuro-oncology Institute actively collaborates with physicians and medical centers globally to exchange knowledge and advance shared experience in combating neuro-oncological pathology.
Medical professionals interested in exploring collaborative opportunities are invited to complete the provided form, and we will respond promptly.